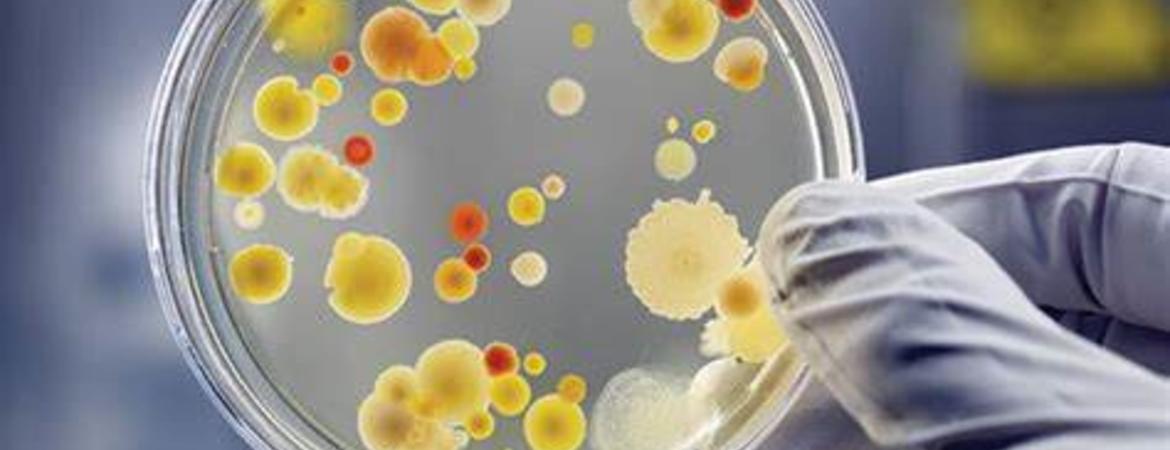

An IIGB/CEPCEB Professor in the Plant Pathology & Microbiology department, Shou-wei Ding, was elected as an American Academy of Microbiology Fellow. The Academy, the honorific leadership group within the American Society for Microbiology, recognizes excellence, originality, and creativity in the microbiological sciences. Awardees are chosen based on their “records of scientific achievement and original contributions that have advanced microbiology.”
Over 2,700 distinguished scientists have been elected to the Academy over the past 50 years by a highly selective, peer-review process. Ding will be recognized at the Academy Fellows Luncheon and Meeting at the 112th ASM General Meeting in San Francisco on Tuesday, June 19, 2012.
Let us help you with your search